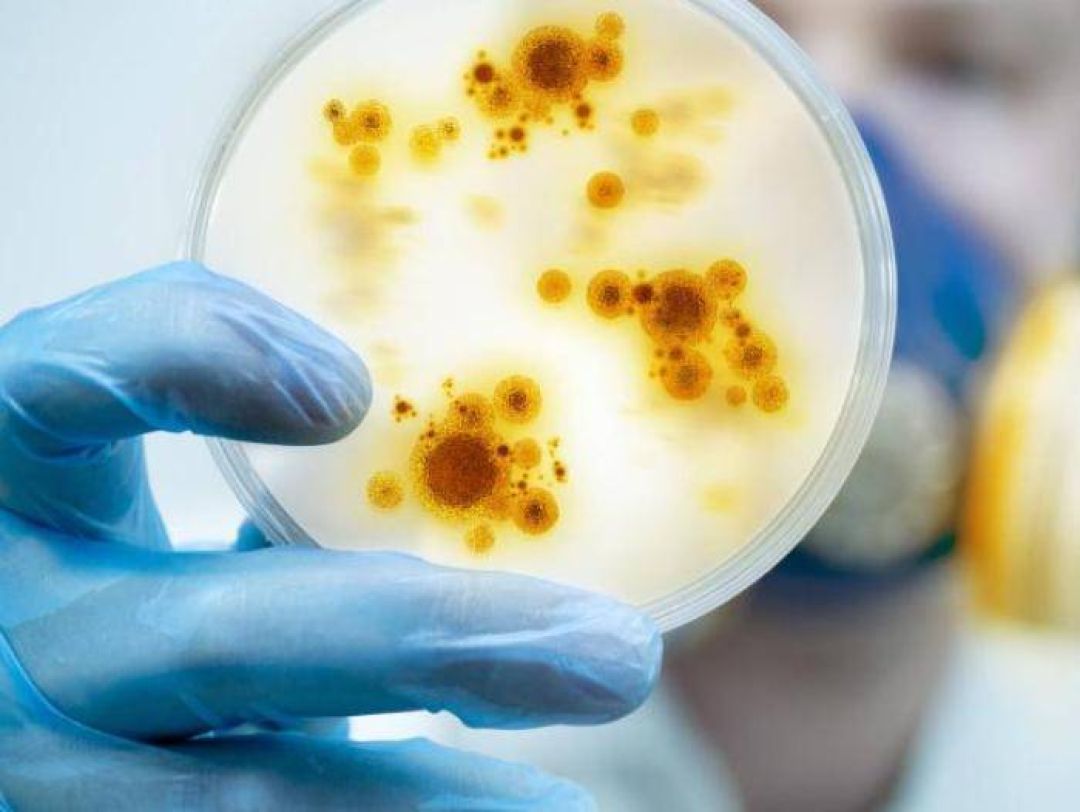

Cumbre de las Américas: EEUU confirma que no ha invitado a Cuba, Nicaragua y Venezuela
El Gobierno de Estados Unidos ha confirmado finalmente que no ha habido cambios de última hora y no ha invitado a la Cumbre de las Américas a las administraciones de Cuba, Nicaragua y Venezuela, au...

Cuentas falsas, bots y spam amenazan compra de Twitter
Elon Musk ha advertido de que se reserva el derecho “a no consumar la transacción” de 44.000 millones de dólares (41.041 millones de euros) para adquirir Twitter en vista de la resistencia ofrecida...

La Comisión Económica para América Latina y el Caribe (Cepal) publicó este lunes su informe sobre pobreza, que señala que pasaría de 29,8% en 2018 a 33,7% este 2022, mientras que en la pobreza extr...

Tras recibir siete disparos de arma de fuego, el ministro de Medio Ambiente de República Dominicana, Orlando Jorge Mera, falleció en su oficina, según informaron medios locales. El presidente domin...

Alemania y Grecia llegaron a un acuerdo para enviar más tanques de guerra a Ucrania
El jefe de gobierno de Alemania, Olaf Scholz, anunció este martes que su país alcanzó un acuerdo con Grecia por el que Atenas enviará vehículos militares de la era soviética a Ucrania a cambio de e...

Johnny Depp gana el juicio por difamación contra Amber Heard
La actriz Amber Heard difamó a su exesposo Johnny Depp al presentarse como una víctima de violencia doméstica, por lo que debe pagarle una indemnización de 15 millones de dólares, concluyó el miérc...

La Justicia Electoral, a través de la Dirección de Servicios Electorales, y mediante Resolución N°19/2022, recuerda a la ciudadanía que se encuentra vigente el periodo de solicitud para acceder a l...

Una multitud acompañó a la reina Isabel II en la celebración de sus 70 años en el trono
En el primer día de los festejos, miles de personas envueltas con banderas de Union Jack, sombreros de fiesta y coronas de plástico se volcaron a las calles del centro de la capital británica para ...

El Papa advierte que la “pobreza material” es “terreno fértil” para las radicalizaciones
Este lunes, el papa Francisco advirtió que las situaciones de «pobreza material», así como la educativa y la espiritual, pueden convertirse en un «terreno fértil» para alimentar radicalizaciones, o...

Descartan enviar a Kiev nuevos sistemas de misiles de largo alcance
Este lunes, el presidente de Estados Unidos, Joe Biden, afirmó que Washington no enviará sistemas de misiles de largo alcance que puedan llegar hasta Rusia, tal como habían informado fuentes del Pe...

El gobernador de Pernambuco, Paulo Camara, informó que la cifra de muertos por las lluvias, aludes e inundaciones que se registran este fin de semana, ascendió a 84, mientras que al menos 56 person...

El Departamento de Justicia de Estados Unidos anunció este domingo que investigará la respuesta policial al tiroteo en una escuela de Uvalde (Texas), en el que el pasado martes murieron 19 niños y ...

Los cuerpos sin vida de dos menores de edad fueron encontrados al interior de un lote baldío en el municipio de Villa de Álvarez, en Colima; ambos habían sido reportados como desaparecidos por sus ...

El presidente de Ucrania, Volodimir Zelenski, visitó por primera vez el este del país desde el inicio de la invasión rusa, con un viaje a la ciudad de Jarkov, la segunda más grande, de cuya perifer...
Estados Unidos planea distribuir vacunas contra la viruela del mono
EEUU desplegará vacunas contra viruela del mono entre la población más susceptible y para ello planea distribuir vacunas de la viruela del mono y tratamientos médicos a los contactos cercanos de pe...

Hay preocupación por el COVID-19 en Pekín
El gobierno de China trasladó el foco de preocupación por la pandemia de COVID-19 hacia Pekín, donde las autoridades centrales reclaman a las locales más medidas que permitan atajar de una vez por ...

España confirma 20 casos positivos de viruela del mono
El Instituto de Salud Carlos III (ISCIII) confirmó 36 casos positivos a orthopoxvirus, de los que 20 se han confirmado como viruela del mono tras la secuenciación parcial del virus y otros 16 casos...

Jair Bolsonaro cuestionó el sistema electoral de Brasil
El presidente de Brasil, el ultraderechista Jair Bolsonaro, volvió a cuestionar este jueves el sistema electoral de su país, a cinco meses de los comicios en los que buscará un segundo mandato.

Millares de costales de fertilizante llenan galpones, entre tractores y maquinaria, listos para la siembra... pero son insuficientes. Una guerra a 10.000 km de distancia tendrá consecuencias en Por...

Reportan brotes de viruela del mono en Norteamérica y Europa
Las autoridades sanitarias de Norteamérica y Europa han detectado decenas de casos sospechosos o confirmados de viruela del mono desde el inicio de mayo, lo que hace temer que la enfermedad, endémi...







